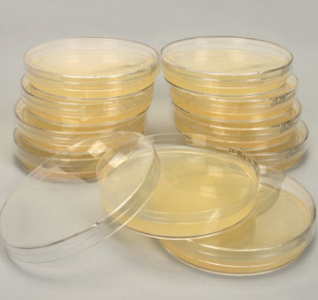

평창군농업기술센터는 지난해 한강유역환경청에 공모한 친환경청정사업에 선정되어 국비 19억 2000만 원을 확보하고 군비 10억 8000만 원을 투자하여 총 32억 원의 사업비를 들여 친환경 유용미생물 배양센터를 건립한다.
배양센터는 농업기술센터 내 부지에 올해 하반기부터 착공하여 실험실, 배양실, 사무실, 저온저장고 등의 시설을 갖춰 2021년 10월 완공될 예정으로, 군농업기술센터는 배양장비 시험가동을 거쳐 2022년부터 본격적인 운영에 들어가면 고초균, 광합성균, 유산균, 호모균 등 연간 약 100톤의 유용미생물을 생산해 농가에 공급할 계획이다.
친환경 유용미생물은 토양 유기질을 분해해 지력을 높이고 생물의 생장 촉진과 병해충 방제에 및 악취 감소에 큰 도움이 되어, 군은 이번 배양센터 건립으로 고품질 친환경 농산물 생산과 농가경영비 절감이 될 것으로 보고 있다.
이만수 농업기술센터소장은 “배양센터 건립으로 친환경 유용 미생물을 농가에 공급하여 주민들에게 안전하고 건강한 먹거리를 제공하고 농가소득 증대로 이어질 수 있도록 최선을 다하겠다”고 말했다.
댓글 영역